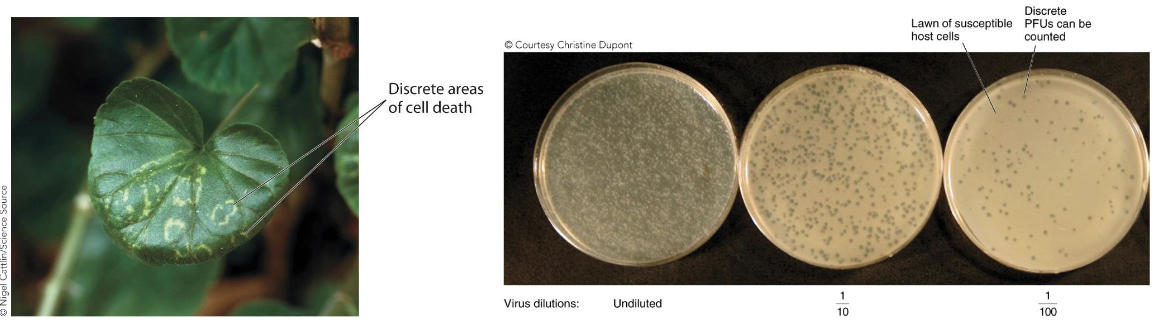
<p>Viral quantification: <strong><em>Plaque assay</em></strong></p><ul><li><p>This is useful in <strong><em>phages</em></strong> and <strong><em>plant viruses.</em></strong></p></li><li><p>Virus is diluted and placed on <strong><em>target cells.</em></strong></p></li><li><p>Plaques are counted to determine <strong><em>plaque-forming unit (PFU) </em></strong>titer of original suspension.</p></li></ul><p></p>

1/41
Looks like no tags are added yet.
Name | Mastery | Learn | Test | Matching | Spaced | Call with Kai |
|---|
No analytics yet
Send a link to your students to track their progress
What is a virus?
History of virology.
Viral diseases have plagued humans since before we even knew what they were (smallpox in Egypt).
It began as a science in late 1800s, when infectious tobacco mosaic virus was isolated in a filtered, bacteria-free fluid by Ivanovski, then Beijerinck.

Who is Walter Reed and his contribution to virology?
Walter Reed showed in 1901 that a human disease, yellow fever, was caused by a virus transmitted by mosquitoes.

What is the structure of viruses?
Viruses are
Intracellular obligate parasites
Typically between 10 and 100 nm
Genomes of DNA or RNA are typically between a few thousand to 200,000 nucleotides in length.
Smallest size: Picornavirus
Largest size: Poxvirus
Complex shape: T4 Bacteriophage, Adenovirus

What are the exceptions to the small size of viruses?
CroV virus of marine single-celled organisms has a 730k bp genome!
Megavirus chilensis (a virus of amoebas) has a genome over 1.2 megabase pairs, encodes 1,200 proteins!
Mimivirus (a dsDNA virus of amoebas) can be 400 nm in diameter, with a 1.2 megabase pair genome coding for 979 proteins!
Minivirus: similar size to a mycoplasm bacteria commonly present in the genital microbiome in humans

What is the structure of viruses?
Single or double-stranded DNA or RNA
Protein shell (capsid) around genome composed of many capsomere proteins
Capsid and genome together = nucleocapsid
Possible envelope (plasma membrane around capsid)
What are the sizes and structural features of selected viruses?
Focus on genetic material (ssRNA vs. dsRNA), variation in genome size and size

What is the symmetry of virus structure?
Structure of viruses: Symmetry
Capsids often exhibit either helical or icosahedral shapes.

What other shapes can viral capsids take on?
Viral capsids can sometimes take on irregular or complex shapes.
Bacteriophages: Tail fibres facilitate binding to host cells
Influenza virus:
Eight RNA segments = Nucleocapsids
Cell envelope
Hemagglutinin (HA)
Neuraminidase (NA)

What is the structure of viral envelopes?
If a plasma membrane surrounds the nucleocapsid, the virus is “enveloped.”
Influenza, HIV
If there is no plasma membrane, the virus is “naked.” (non-enveloped)

What is the replication cycle for viruses?
Briefly, a virus must
Stick to a host cell (adhere)
Get into the cell (penetrate) and release its genome (uncoat)
Express its genes to make proteins (synthesis)
Replicate its genome (synthesis)
Put everything together (assembly) and get the new virus particles out (exit)

What is the entry stage for viral replication?
Entry is arguably the most important part in the viral replication cycle.
Mechanisms for entry vary depending on the host cell.
Animal viruses don’t have to contend with a cell wall structure.
Plant, fungal, and bacterial viruses do.
What is the entry into animal cells?
Non-enveloped: Endocytosis
Enveloped (HIV): Membrane fusion
Enveloped (Influenza A): Endocytosis → Fusion (envelop and vesicle membrane)

What is the entry into plant cells?
Often depends on some damage to the plant tissues to open a spot in the cell wall
Insects feeding on plants
Wind damage
Hail/rain damage
Fire damage
Human-induced damage
What is the entry into bacteria?
Tail fibres attach to receptors
Conformational change in tail fibers bring base of the tail in contact with host cell surface
Rearrangement of tail proteins allows inner core tube proteins to extend down into cell wall
Contact with the plasma membrane initiates transfer of DNA through a pore formed in the lipid bilayer

How did viruses originate?
The evolutionary history of viruses isn’t very clear, but three hypotheses have emerged:
Coevolution
Regressive
Progressive
What is the coevolution hypothesis?
Viruses evolved along with their host cells.
This could explain the origin of many RNA viruses.
There is little supporting evidence as of yet.
What is the regressive hypothesis?
Viruses are cells that lost some of the replicative and metabolic traits over time.
Examples of this phenomenon exist in the biological world.
This doesn’t adequately explain origins of RNA viruses.
What is the progressive hypothesis?
Existing genetic elements gradually gained the ability to move from cell to cell.
Evidence in the form of transposons (for DNA viruses) and retrotransposons (for retroviruses)

How can we grow and quantify viruses?
Viruses are much trickier to work with than bacteria.
They are very small.
They only replicate within appropriate host cells.
Because of these traits, various strategies are used to amplify and quantify viruses
What are the types of bacteriophages?
Viral cultivation : Two types of bacteriophages
Lytic: Phages will replicate in and burst open (lyse) the host cells.
Lysogenic: Phages can integrate their genome into the host cell genome (becoming a prophage) and be replicated each time the host cell replicates
What are the steps of turbid → clear media?
A small volume of susceptible bacterial host cells is added to the phage sample
The mixture is added to molten nutrient agar and quickly mixed
The agar mixture is poured onto a nutrient agar base and allowed to solidify
Plaques appear after sufficient incubation.

What is viral cultivation for animal viruses?
Tissue culture of host cells must be used to grow the targets for the viruses.
These cultures must be kept sterile and bacteria-free (see Toolbox 5.1).
These methods have only been in place since the 1950s.
Modern virology couldn’t exist without these tools.
Many of these tools developed from the first human cell line, known as HeLa cells (named after the woman they were originally isolated from, Henrietta Lacks).
Henrietta Lacks: The 'immortal' cells that changed the world - BBC REEL

What are the differences in the tissue culture?
Tissue culture of host cells must be used to grow the targets for the viruses.
Cytopathic effects (CPE) can be observed in virally infected cultured cells (ex: fused cells = syncytia)

What is viral purification?
This usually begins with simple filtration to remove large cells and cellular debris.
Then viruses can be purified and concentrated with differential centrifugation (seen below) or gradient centrifugation.

What is gradient centrifugation?
Depends on different densities of viral components and particles
Each piece of different density will settle into a different area (“band”) of a density gradient after centrifugation (see the Mini-Paper in this chapter for an example of this useful technique).

What is viral quantification?
Not easy or straightforward
Usually measured as a titer, or concentration of a virus preparation
Methods include
Direct count
Hemagglutination assay
Plaque assay
Endpoint assays
What is Direct Count?
Viral quantification: Direct count
An electron microscope can be used to visualize a known volume of material, counting viruses within it and scaling up to determine titer.
Not easy!
Requires an expensive, specialized microscope
Doesn’t differentiate between infectious and noninfectious viral particles
What is Hemagglutination assay?
Viral quantification: Hemagglutination assay
Exploits trait of some viruses to stick to red blood cells (RBCs), causing them to form a gel mat (shield)
Pros: Cheap, easy, fast; no microscope needed
Cons: Some viruses won’t do this; doesn’t differentiate viable/nonviable viruses; doesn’t give a virus number

What is Plaque assay?
Viral quantification: Plaque assay
This is useful in phages and plant viruses.
Virus is diluted and placed on target cells.
Plaques are counted to determine plaque-forming unit (PFU) titer of original suspension.
What is Endpoint assays?
Viral quantification: Endpoint assays
Tissue culture infectious dose 50 (TCID50): Amount of virus needed to induce a CPE in 50% of cultured cells
Lethal dose 50 (LD50): Amount of virus needed to kill 50% of test animal subjects

What are different types of viruses?
Virus names:
Historically, quite varied!
Simple letter/number combinations (T4 phage)
Organism(s) they infect (tobacco mosaic virus)
Location of discovery (Ebola River, Zaire)
Appearance (coronavirus, “crown”)
Disease caused (hepatitis viruses

What are the different strategies used to name viruses?
Location
Disease
Physical characteristic

What is the ICTV classification scheme?
Viral classification
ICTV = International Committee on Taxonomy of Viruses
Classify viruses based on Order, Family, Subfamily, Genus, and Species
Because all viruses do not possess a common gene, a universal classification scheme is problematic
What is the Baltimore classification system?
Developed by Nobel laureate David Baltimore
Based around mRNA production methods
Separates viruses into seven classes
What do members within a family share?
Members within a family (suffix -viridae): share virion structure, genome organization, transcription/translation strategies

What is the criterion to define a species?
Criteria to define species: host range, cell and tissue tropism (infection ability), pathogenicity, antigenicity, nucleic acid sequence relatedness

What is Electron microscopy?
Virus identification
The first step in identification rests on visual observation of viral morphology (not infallible)

What is Nucleic acid analysis?
Polymerase chain reaction (PCR) and reverse- transcriptase PCR (R T-PCR, see Toolbox 5.2)
Can be used to identify viruses by genome sequence
Can be used to study viral evolution patterns

What is RT-PCR?
A side note on RT-PCR:
This method is incredibly useful.
It is an adaptation of the PCR method discussed in Chapter 1.
It uses an enzyme discovered in viruses in the 1970s by Baltimore and Temin.
This enzyme takes RNA and converts it into DNA.
DNA is more stable than RNA.
DNA can then be amplified using the PCR process.
This method allows scientists to study the RNA molecules produced by cells and viruses infecting them.
How does RT-PCR work?
RNA is isolated.
Primer, RT, nucleotides are added.
RT makes a complementary DNA copy of the RNA.
Sample is heated to denature strands and inactivate RT.
Primers, Taq pol, and nucleotides are added.
Taq pol makes a second DNA strand.
Further PCR cycles can amplify the amount of DNA produced.

What’s next for virology?
Unsurprisingly, virology and medicine are closely involved.
Virology examines cancer-causing oncoviruses.
Virology examines cancer-destroying oncolytic viruses.
Viruses can even be exploited to deliver working copies of genes to replace damaged versions (gene therapy, experimental)

How are virology and medicine linked?
Unsurprisingly, virology and medicine are closely involved.
Virology continues to be involved in examination of new and emerging global diseases (e.g., HIV)
~35 million people infected with HIV
